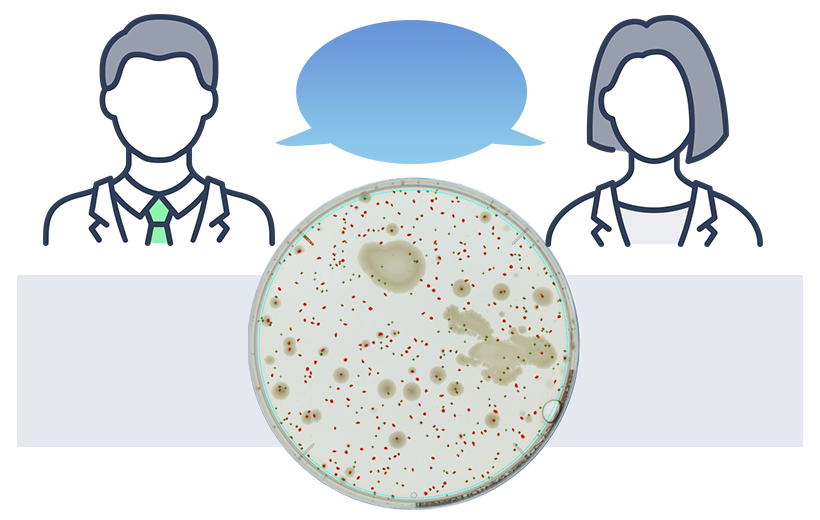

Zählung und Dokumentation auf Knopfdruck
Legen Sie einfach die Platte auf den Objekttisch, um innerhalb einer Sekunde Ergebnisse auf Knopfdruck zu erhalten.
Das System verfügt über voreingestellte optimale Prüfeinstellungen für bestimmte Nährmedien und andere Faktoren, weshalb auch unerfahrene Anwender Zählungen durchführen können.